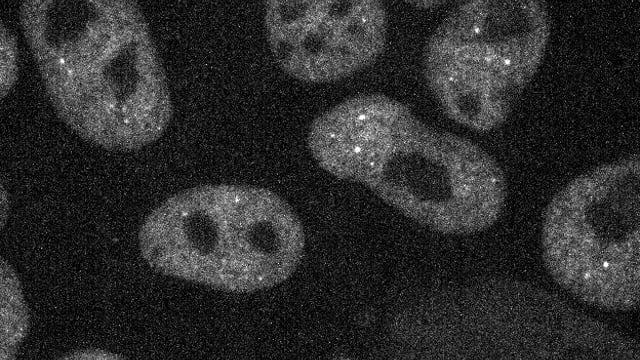
Video thumbnail
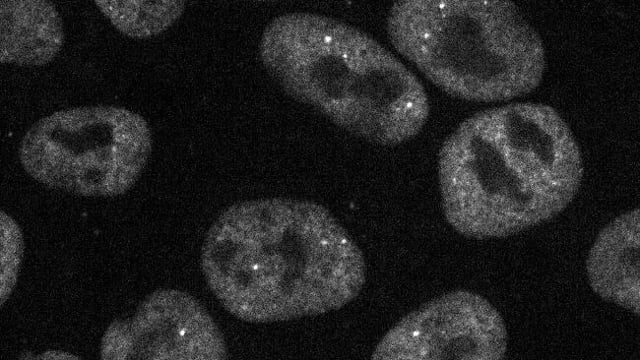
Video thumbnail
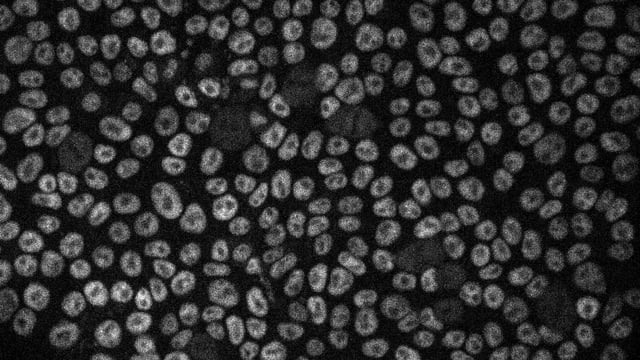
Video thumbnail

NCBI Isoforms:n |
crRNA Target Site:CGCCTGCCTCCGCCATGCAC |
Linker: SGLRSRAQASNSAVDGTAGPGSTGSS |
Cas9:Wildtype spCas9 |
AICS-0096
POLR2A in WTC-mEGFP (mono-allelic tag)
Single, mid-level plane of cells in a live hiPS cell colony expressing mEGFP-tagged RPB1. Cells were imaged in 3D on a spinning-disk confocal microscope. Scale bar, 50μm

EditingDesign
GenomicCharacterization
StemCellCharacteristics
mEGFP Insert

